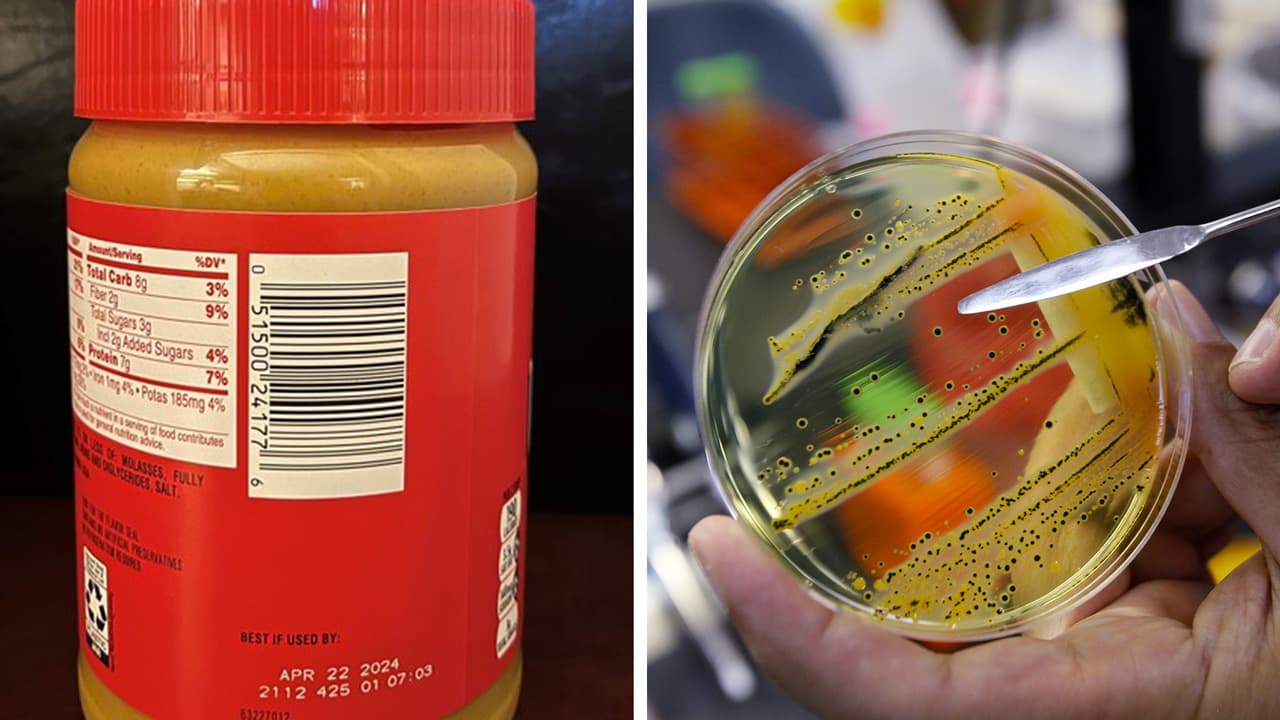
Revisa la mantequilla de maní que tienes en casa: podrías enfermar de salmonela

Estado de Virginia
Estado de Virginia : Últimas noticias, videos y fotos de Estado de Virginia
¿Necesitas apoyo para tu salud mental en Alexandria? Te decimos dónde acudir por ayuda gratuita
Los estudiantes de Alexandria, Virginia, y sus familiares, tienen disponible una red de recursos gratuitos para apoyo a su salud mental, tras la tragedia que cobró la vida de Luis Mejía, un joven hispano apuñalado en el Centro Comercial Bradlee.
LO MÁS RECIENTE

Arrestan a joven de 16 años, acusado de asesinato por apuñalamiento a hispano en Alexandria
La Policía de Alexandria arrestó a un joven vinculado con la muerte de Luis Mejía, un hispano de 18 años que murió por arma blanca hace una semana en una pelea colectiva.

Policía de Alexandria arresta a adolescente por la muerte de un hispano apuñalado en pelea masiva
Un joven de 16 quedó bajo arresto por la muerte de Luis Mejía, un hispano de 18 años que fue apuñalado en una pelea masiva en Alexandria el 24 de mayo, informó la Policía local.

Padre de Luis Mejía denuncia fallas de la Policía alrededor de la muerte de su hijo
Osmin Mejía cree que la Policía no actuó de forma correcta durante la riña donde su hijo, Luis, de 18 años, fue apuñalado y perdió la vida en Alexandria, Virginia.

Video capta pelea grupal en la que murió un hispano de 18 años en Alexandria
Luis Mejía, de 18 años, murió apuñalado durante una pelea en la que participaron de 30 a 50 jóvenes en Alexandria, Virginia. El suceso quedó grabado en videos.
Captan en video pelea masiva en la que un joven hispano murió apuñalado en Virginia
Videos de una pelea de hasta 50 jóvenes en Alexandria City muestran el momento en el que un joven murió apuñalado el 24 de mayo; su padre exige justicia.

¿Son seguras las escuelas del DMV? Cifras de tiroteos de 2013 a la fecha en DC, Maryland y Virginia
Aunque en el área del DMV no se han registrado tiroteos de la magnitud del ocurrido hace una semana en Uvalde, Texas, sí hay incidentes, incluso recientes, con el uso de armas de fuego y víctimas mortales.